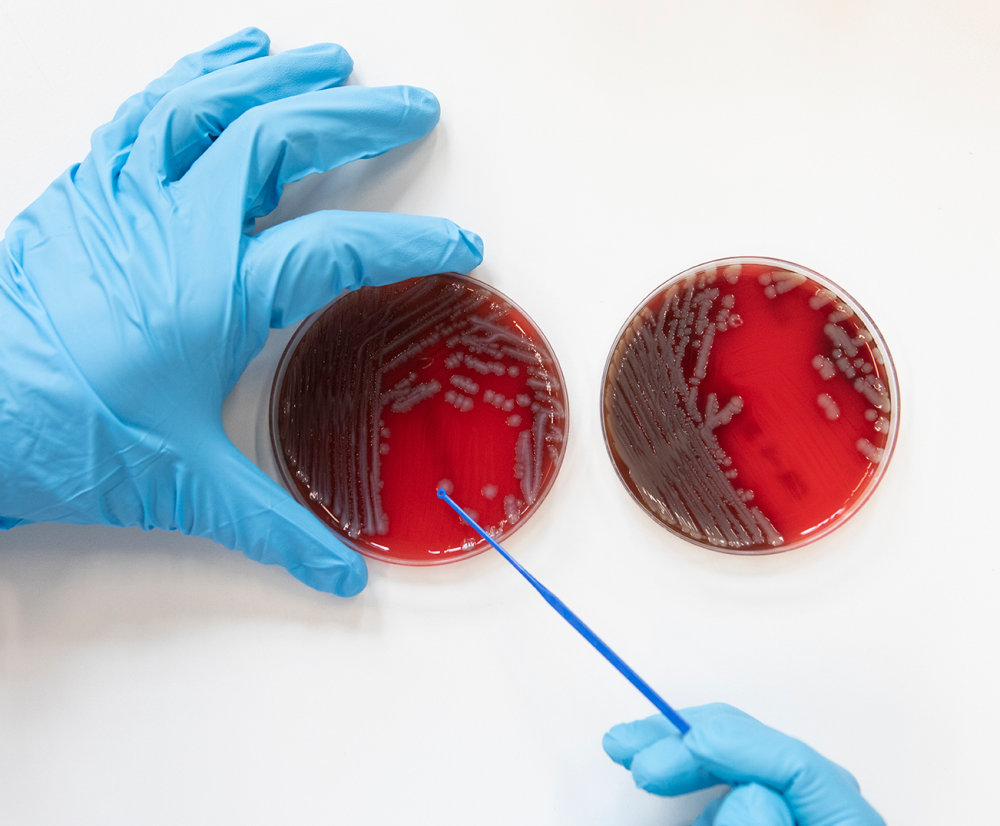

"AI gives scientists superpowers — but also super responsibilities"

Oren Tzfadia is a senior researcher in Computational Biology at the Department of Biomedical Sciences of the Institute of Tropical Medicine in Antwerp. He is driven to find out how our genes work and uses algorithms and big data to discover new things about how genes function. In particular: the fight against drug-resistant tuberculosis – globally still one of the most deadliest diseases. He will give a keynote on the topic at the upcoming ITM Colloquium.

We hear a lot about “omics” nowadays in health research. What are they and why are they so important?
OREN TZFADIA: Instead of studying one gene or pathway at a time, we look at the entire organism. This approach is called omics. A gene is a piece of DNA that contains the information to be translated to RNA and then to make a specific protein. These proteins control and regulate how the body works. When a gene is altered or mutated, it can have an effect on how a protein functions. Genetic testing helps identify whether certain genes are responsible for disease development and treatment outcome.
Advances in technology now allow us to sequence all genes (genome), monitor RNA levels (transcriptome) and analyze all proteins (proteome). Think of it as moving from listening to a single musician to hearing a whole orchestra. This gives us a complete picture of the biological processes at play.
Omics has become a buzzword because we finally have the technology and analytical tools to generate and analyze massive datasets. AI and computing power allow advancement to conduct multi-layered studies, which is revolutionizing biology research. It gives us the ability to make discoveries that weren’t possible before.

What kind of discoveries?
OREN: For example, we use it to tackle drug-resistant tuberculosis, a disease which still kills 1.5 million people every year. There are different strains of tuberculosis, much like with the coronavirus. There are seven types of antibiotics that treat it, but for some patients, those medicines no longer work. That’s a big problem - we’re already seeing samples that are resistant even to the most recent antibiotics.
Tackling that problem is complex. When we look at the drug-resistant strains of tuberculosis, we don’t always see a direct link between the antibiotics and the strain’s genetic mutations responsible for the resistance. We’re still puzzled by why this happens. Now, by combining different layers of omics from the same sample, we’re trying to uncover what that indirect link might be - the one we don’t see directly.
And how do you use AI and new technologies for this?
OREN: We’re feeding all the information we have – published papers, experimental data and other relevant data - into an AI model. We think AI might help find the connections between drug-resistant strains and the antibiotics that we can’t see directly. Maybe it can help us understand why drug resistance occurs.
AI also helps us work much faster and get results more quickly. For instance, determining whether a sample is drug-resistant usually takes six or seven weeks, because we have to grow the mycobacteria. With AI, we can take continuous pictures of the bacteria under a microscope. The model analyzes the growth patterns, and after only a few hours, resistance can already be detected - long before it’s visible to the naked eye. That’s a great example of how AI technology can boost our research.
Of course, it is always essential to keep humans in the loop to verify AI’s output. We need to remember: AI gives us superpowers, but it also gives us super responsibilities.

What would you say to scientists who hesitate to use AI?
OREN: I hope other scientists aren’t reluctant to use AI and new technologies. Honestly, I think this will become the normal way of doing science, so it’s best to keep up with the rest of the world. Everyone is going to have these superpowers.
We already see this with our students. Our biology students need to learn programming, and our programmer students need to learn biology. It used to take about ten months to train students to the level we needed, but now, they can start working from day one. AI can do the coding, or summarize the ten latest papers for me. It really impacts every aspect of our work.
Do you see limitations of these new technologies?
OREN: Yes, omics and AI aren’t magic bullets, they have to be combined with strong local partnerships in the Global South. They can help us ask better questions, find smarter solutions and bring precision medicine to where it’s needed most. Technology alone won’t fix weak systems - for example, in low- and middle-income countries. The real innovation is pairing new tools with equity, local ownership and sustainable integration.
If technology is parachuted into or imposed on local systems, it’s like giving someone a Ferrari without fuel - what can they do with it? That’s why we co-develop bioinformatics training and data platforms with local scientists, so they can independently use omics and guide their own public health policies.
Spread the word! Share this story on









